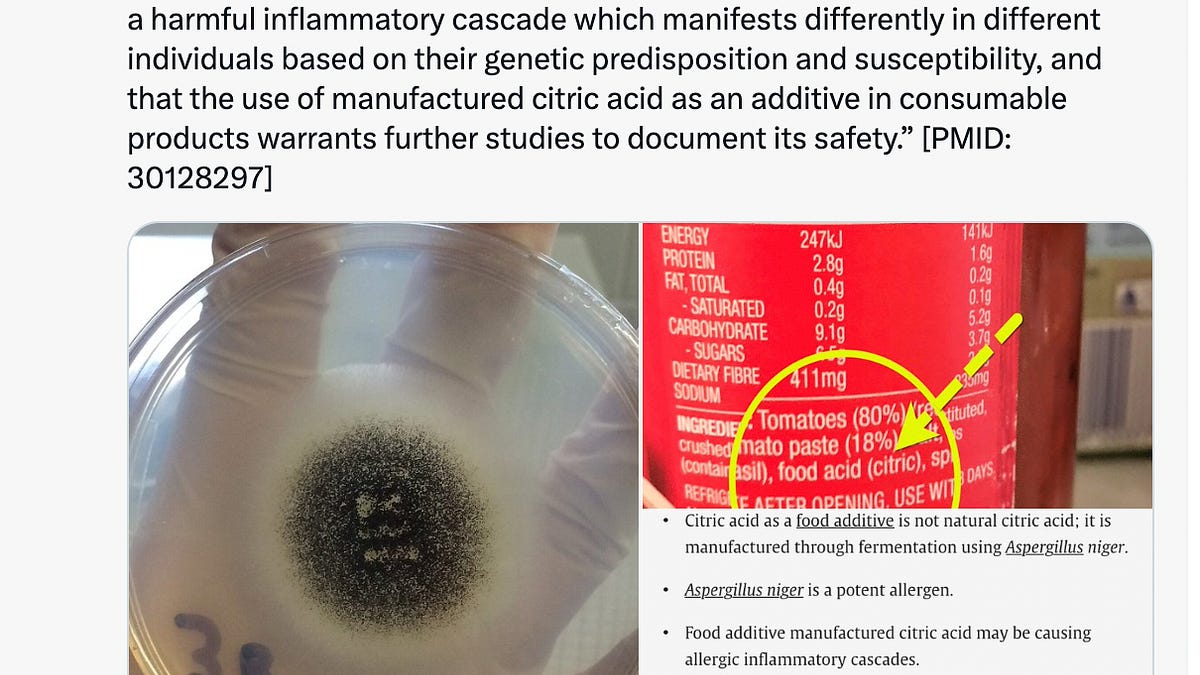
celiafarber.substack.com

Neither I use Boars head brand I've never made pesto,at least I can't rememberDo you make yours with walnuts or pine nuts?
-
 You must be logged in to see or use the Shoutbox. Besides, if you haven't registered, you really should. It's quick and it will make your life a little better. Trust me. So just register and make yourself at home with like-minded individuals who share either your morbid curiousity or sense of gallows humor.
You must be logged in to see or use the Shoutbox. Besides, if you haven't registered, you really should. It's quick and it will make your life a little better. Trust me. So just register and make yourself at home with like-minded individuals who share either your morbid curiousity or sense of gallows humor.
You are using an out of date browser. It may not display this or other websites correctly.
You should upgrade or use an alternative browser.
You should upgrade or use an alternative browser.
- Thread starter swivel
- Start date
I now make my own marinara, but while it simmers I head to my local corner bar for their happy hour.
Their happy hour is 1 pint, plus a half pint, from any tap for $5. Today I got a Lagunitas IPA and a half pint of Astrodon Hazy IPA.

Sorry of the late post on this. I guess when I thought I sent it out at the bar it actually did not.
Their happy hour is 1 pint, plus a half pint, from any tap for $5. Today I got a Lagunitas IPA and a half pint of Astrodon Hazy IPA.
Sorry of the late post on this. I guess when I thought I sent it out at the bar it actually did not.
VLGRDSPLY
Trusted Member
plain? or with hot dogs or meatballs? (yes it matters) also did you add cheese??? (I like my o's a lil gourmet...Spaghettio's
I had frozen Stouffers mac n cheese.... shits so good! (edited to say, I cooked it, it was no longer frozen)
Actually I don't like them,but I love me some Stouffers, the lasagna really is delicious with a load of garlic bread,does a real number on my sugar but IDGAF. I also like beanie weeniesplain? or with hot dogs or meatballs? (yes it matters) also did you add cheese??? (I like my o's a lil gourmet...
I had frozen Stouffers mac n cheese.... shits so good! (edited to say, I cooked it, it was no longer frozen)
VLGRDSPLY
Trusted Member
I have never had the actual brand beenie weenies, but I do buy cans of baked beans n add sliced up hot dogs, good n cheap... Not a fan of spaghetti o's either my kid likes the one with hot dogs... I would rather with the meatballs, and then I add american cheese to help with the gross flavor of the sauce... I do love beefaroni with american cheese though!
I love pretty much all the stouffers frozen shit.... but I eat the mac n cheese prob twice a week for lunch, its quick n easy...
I love pretty much all the stouffers frozen shit.... but I eat the mac n cheese prob twice a week for lunch, its quick n easy...
everjaded
ಠ_ಠ
We've been on carnivore for awhile, but are having a cheat weekend since we'll be eating at my parent's for Easter and cheating then anyway. Tonight had steak hibachi from our former favorite local place, and made a few peanut butter chocolate chip break and bake cookies for dessert.
Baked an apple cake and cooked the old family recipe baked beans to take over tomorrow. It smells so amazing in my house after all this time of only cooking meat and eggs.
Baked an apple cake and cooked the old family recipe baked beans to take over tomorrow. It smells so amazing in my house after all this time of only cooking meat and eggs.
A Sour Deception: Mass produced Citric Acid comes from GMO black mold

 celiafarber.substack.com
celiafarber.substack.com
New Movement And New Acronym Invented: MYHA--Make Yourself Healthy Again—Use Mind And Instinct
MYHA First Post: Citric Acid, A Ubiquitous Ingredient, Is A Synthetic, Genetically Modified Form Of BLACK MOLD—Did Any Of Your Healers, Influencers, De-Tox Leaders, etc Ever Tell You THIS?
the cat did it
Trusted Member
I LOVE beanie weenies. I would even get it for lunch sometimes in my thermos when I was a kid-whatever did not fit in the thermos I finished off for breakfast-good ole days, and spagetti o's with meatballs only please and thank you!Actually I don't like them,but I love me some Stouffers, the lasagna really is delicious with a load of garlic bread,does a real number on my sugar but IDGAF. I also like beanie weenies
Again meatballs only for me and the actual beenie weenie brand is really good too. And I have a soft spot for beefaroni-and if I have some taco bell packets-hot or mild I add it to my beefaroni, "kicks it up a notch"-so good.I have never had the actual brand beenie weenies, but I do buy cans of baked beans n add sliced up hot dogs, good n cheap... Not a fan of spaghetti o's either my kid likes the one with hot dogs... I would rather with the meatballs, and then I add american cheese to help with the gross flavor of the sauce... I do love beefaroni with american cheese though!
I love pretty much all the stouffers frozen shit.... but I eat the mac n cheese prob twice a week for lunch, its quick n easy...
tonight is cheese and meat ravioli "lasagna" with very buttery garlic bread on garlic and herb bread- we ate ham all week, bought it too early and everyone bugged me to cook it, we did not make it to Easter

